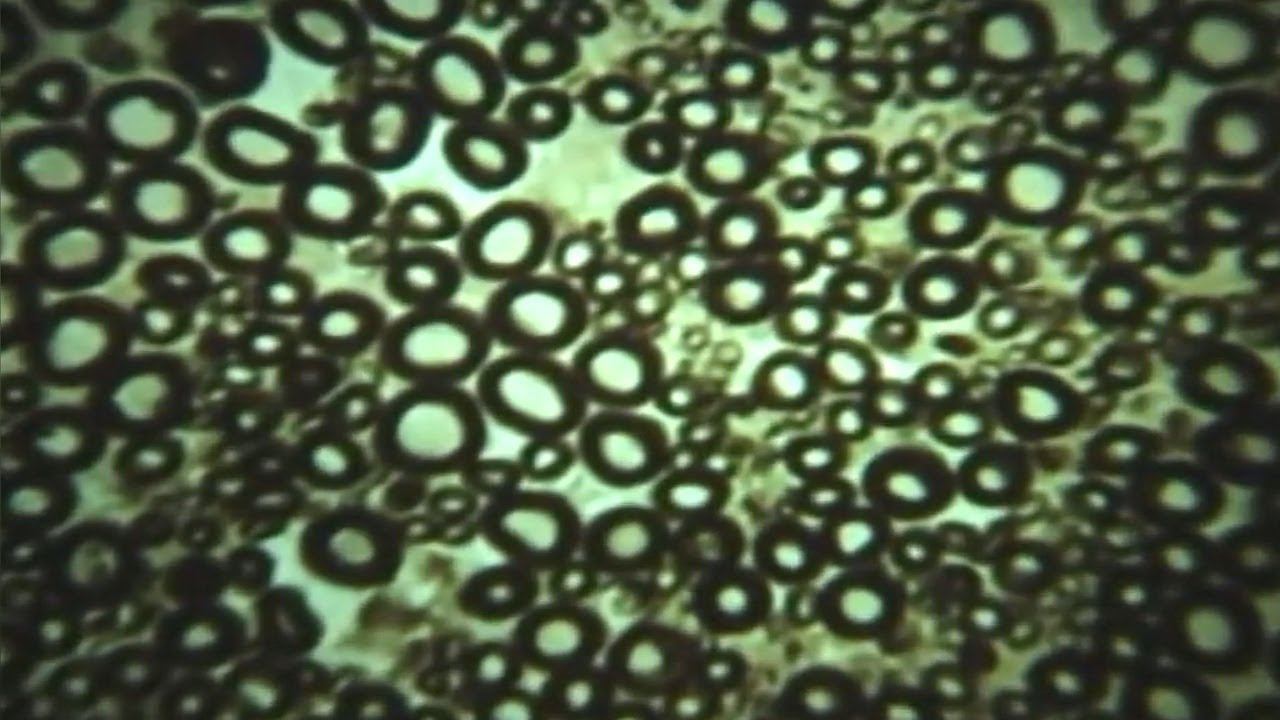
Общая анатомия проводящих путей. (stopsoznanie.ru)

СТОП СОЗНАНИЕ - Новые видео
-
-
-
"Спрайты" | "Джеты" | "Эльфы"
Черновик для сайта - stopsoznanie.ru Источник видео: Канал "29cbetlana29"__"Охотники за молниями / Lightning chasers" https://youtu.be/aMr9a7dW0qo
Смотреть -
-
Распил куска гранита (stopsoznanie.ru)
Видео для заметки "Великая пирамида" https://stopsoznanie.ru/velikaya-piramida.html на сайте СТОП СОЗНАНИЕ. Цитата из заметки: "Согласитесь, что в качес...
Смотреть -
"НЕТ, это невозможно!" (stopsoznanie.ru)
Видео для заметки "Великая пирамида" https://stopsoznanie.ru/velikaya-piramida.html на сайте СТОП СОЗНАНИЕ Источник видео: Proto Civilization / ПротоЦи...
Смотреть -
"ДА, это возможно!" (stopsoznanie.ru)
Видео для заметки "Великая пирамида" https://stopsoznanie.ru/velikaya-piramida.html на сайте СТОП СОЗНАНИЕ. Цитата из заметки: "Для одних благодаря рабо...
Смотреть -
Бояться смерти — это...
Черновик для сайта - stopsoznanie.ru Бояться смерти — это ничто иное, как приписывать себе мудрость, которой не обладаешь, то есть возомнить, будто зна...
Смотреть -
-
Эксперимент Милгрэма (stopsoznanie.ru)
Результаты эксперимента: "Человеческая природа не может противостоять приказу легитимного авторитета и, таким образом, не в состоянии защитить людей от ...
Смотреть -
[36] - Закон разрыва шаблона. (stopsoznanie.ru)
Доцент кафедры общей психологии Валерия Юльевна Карпинская. Цитата из лекции: "...сегодня же мы рассмотрим, как изменяется контекст, и то, как это изме...
Смотреть -
[37] - Нарушение контекста. (stopsoznanie.ru)
Цитата из лекции: "...Реальные ощущения настолько противоречат ожиданиям, что даже если человек хорошо информирован о том, что должно произойти, всё рав...
Смотреть -
[51] - Как возникают критерии точности соответствия. (stopsoznanie.ru)
Цитата из лекции: "Критерии нужно создать, создаются они в процессе подтверждения собственных гипотез и ожиданий. Сначала требования к точности соответс...
Смотреть -
|61] - Сознание не терпит пустоты. (stopsoznanie.ru)
Цитата из лекции: "Оказалось, что это состояние является чрезвычайно трудно переносимым. Практически никто не выдержал в такой камере более чем 72 часа,...
Смотреть -
Защитный механизм сознания (stopsoznanie.ru)
Цитата из предисловия сайта СТОП СОЗНАНИЕ stopsoznanie.ru "Просматривая статьи/заметки на этом сайте, не ставьте перед собой задачи по решению тех воп...
Смотреть -
[29] - Структурирование реальности. (stopsoznanie.ru)
Цитата из лекции: "Закон Юма гласит, что - случайный выбор является субъективно неслучайным... ...Процедура которую мы сейчас с Вами проделали называетс...
Смотреть -
"Провода" спинного мозга. (stopsoznanie.ru)
Видео для заметки "Биологический механизм" на сайте СТОП СОЗНАНИЕ https://stopsoznanie.ru/biologicheskiy-mekhanizm/biologicheskiy-mekhanizm.html Цитат...
Смотреть -
Общая анатомия проводящих путей. (stopsoznanie.ru)
Видео для заметки "Биологический механизм" на сайте СТОП СОЗНАНИЕ https://stopsoznanie.ru/biologicheskiy-mekhanizm/biologicheskiy-mekhanizm.html Цитат...
Смотреть -
"Провода" головного мозга. (stopsoznanie.ru)
Видео для заметки "Биологический механизм" на сайте СТОП СОЗНАНИЕ https://stopsoznanie.ru/biologicheskiy-mekhanizm/biologicheskiy-mekhanizm.html Цитат...
Смотреть -
Весь курс лекций по психологии сознания в одном видео. (stopsoznanie.ru)
Цитата из завершающей лекции: "Общество потребления - это общество для организма, а как же сознание? Если мы будем понимать, что самое главное, что мы д...
Смотреть










![[36] - Закон разрыва шаблона. (stopsoznanie.ru)](https://pic.rtbcdn.ru/video/bf/bf/bfbf0628c1bf7dfbde5bc7238354fa2c.jpg)
![[37] - Нарушение контекста. (stopsoznanie.ru)](https://pic.rtbcdn.ru/video/61/3a/613a78ef5400ad583df43026793119b1.jpg)
![[51] - Как возникают критерии точности соответствия. (stopsoznanie.ru)](https://pic.rtbcdn.ru/video/ea/73/ea7322f7a0ff55f56a4fa0552002e8cb.jpg)
![|61] - Сознание не терпит пустоты. (stopsoznanie.ru)](https://pic.rtbcdn.ru/video/8d/61/8d6184a90f9ec26f98a2539bddf5e31d.jpg)

![[29] - Структурирование реальности. (stopsoznanie.ru)](https://pic.rtbcdn.ru/video/17/e3/17e32c288e3921ff9ccd6a057c576e06.jpg)